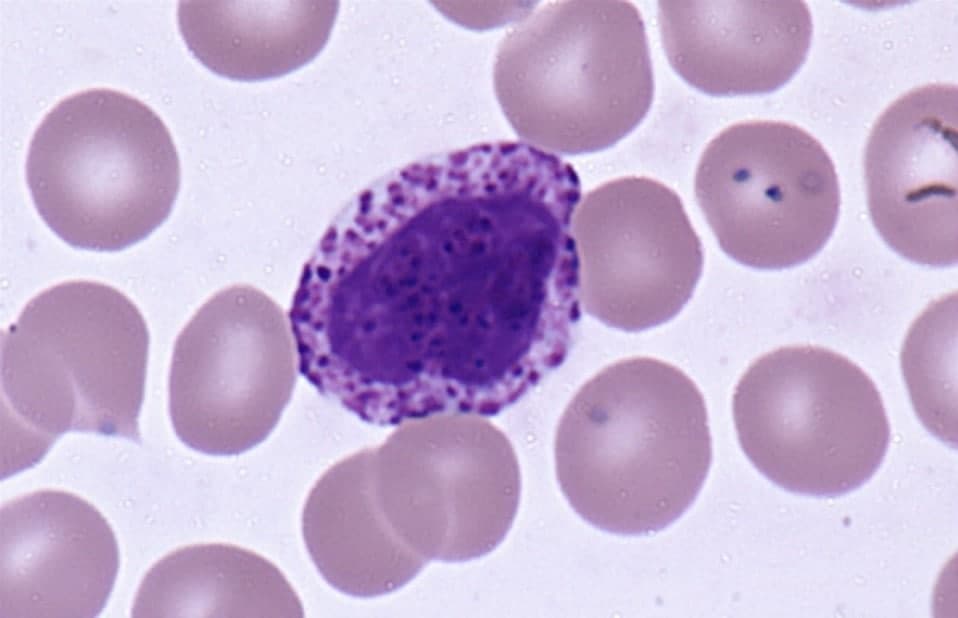
عمومی عمومی

عمومی
- مهر- ۱۴۰۲ -۲۹ مهر

برخی بانکهای ایرانی در خدمت سایتهای شرطبندی
به نقل از فارس نیوز، براساس گزارشات مردمی در سامانه سوتزنی خبرگزاری فارس، سایتهای شرطبندی به صورت علنی قمار را…
- ۲۹ مهر

۹۲ کشور مشتری کالاهای آذربایجان شرقی هستند – خبرگزاری آنلاین | اخبار ایران و جهان
به گزارش خبرگزاری آنلاین، محمدجعفر عظمائی روز شنبه در گفتوگو با خبرنگاران اظهار کرد: افزایش ۳۰ برابری صادرات غیرنفتی آذربایجان…
- ۲۹ مهر

کودک کشی بمثابه یک سلاح
در یکماه اخیر صهیونیستها حملات خود به مسجد الاقصی را چند برابر کردند و بارها حرمت شکستند؛ مرابطات (زنان معتکف…
- ۲۹ مهر

معرفی انواع آچار
معرفی انواع آچار و کاربرد هر کدام بجز بکس بادی و جغجغه بادی؛ یکی از ابزار آلات کاربردی که شاهد…
- ۲۸ مهر

علائم آزمایش خون
آیا پس از انجام خدمت با ، نیاز به تفسیر نتیجه آزمایش خود پیدا کردهاید؟ آیا تا به حال بعد…
- ۲۸ مهر

قهرمان بدون ضدقهرمان هیچ است!
یکی از مباحث فلسفی که ظهور آن را امروزه در عالم داستاننویسی به خصوص در سینما و انیمیشن میبینیم، مساله…
- ۲۸ مهر

مراسم یادبود شهدای غزه از سوی مراجع تقلید در قم برگزار شد – خبرگزاری آنلاین | اخبار ایران و جهان
به گزارش خبرنگار آنلاین، مراسم حمایت و همدردی با مردم مظلوم فلسطین و یادبود شهدای غزه شامگاه پنجشنبه از سوی…
- ۲۷ مهر

جنگ حماس و اسرائیل؛ سناریوهای احتمالی آینده
حمله ای که جهان را شگفت زده کرد و سایر بحرانها و جنگهای مهم همچون جنگ روسیه و اوکراین و…
- ۲۷ مهر
bas در آزمایش خون چیست
همچنین با استفاده از خدمت آزمایش در منزل هومکا میتوانید بسیاری از انواع آزمایش خون را در خانه یا محل…
- ۲۷ مهر

دهمین همایش اقتصاد مقاومتی برگزار میشود
دهمین همایش سالانه اقتصاد مقاومتی با موضوع «حکمرانی ارزی؛ ثبات و رونق اقتصادی» برگزار میشود. به گزارش بازتاب روز، این همایش سالانه توسط…